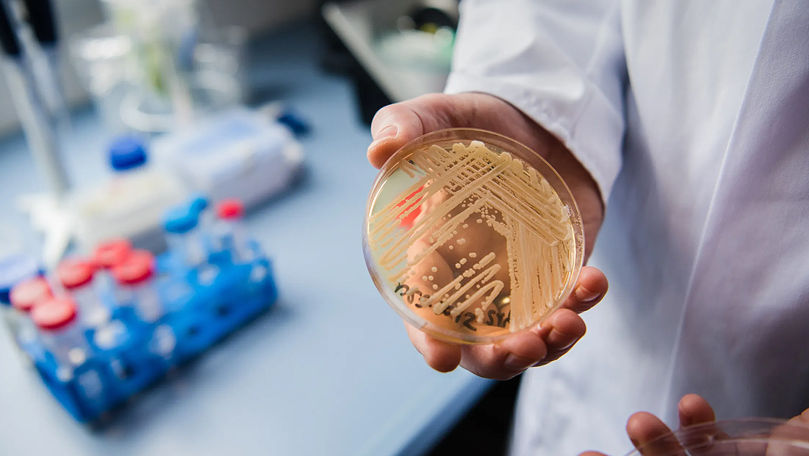
Смертельная грибковая инфекция, устойчивая к лекарствам, распространяется по больницам Европы.

Смертельная грибковая инфекция, устойчивая к лекарствам, распространяется по больницам Европы
Опасная лекарственно-устойчивая грибковая инфекция быстро распространяется в больницах по всей Европе, предупредил ведущий европейский орган здравоохранения.
Европейский центр по контролю и профилактике заболеваний (ECDC) сообщил в докладе, опубликованном в четверг, что с 2013 по 2023 год грибком Candidozyma auris (C.auris) заразились более 4000 человек. Только в 2023 году было зарегистрировано 1346 случаев — это на 67% больше по сравнению с предыдущим годом, передает theins.ru со ссылкой на telegraph.co.uk
Агентство отметило:
«Число случаев растет, вспышки увеличиваются в масштабах, и несколько стран сообщают о продолжающейся местной передаче инфекции».
C.auris, ранее известный как Candida auris, обычно распространяется в медицинских учреждениях и в основном поражает людей, которые уже находятся в критическом состоянии. Грибок может вызывать серьезные инфекции крови, головного и спинного мозга, костей и ушей, а также поражать дыхательную и мочевыводящую системы. Почти 60% людей, заразившихся C.auris, умирают в течение 90 дней.
Грибок выработал устойчивость к большинству противогрибковых препаратов, что делает его лечение крайне сложным. Он также может долго выживать на различных поверхностях и медицинском оборудовании и устойчив к большинству дезинфицирующих средств. В Великобритании при отборе проб в больницах по всей стране следы грибка обнаружили на батареях, подоконниках, раковинах и медицинском оборудовании — термометрах, тонометрах и стетоскопах.
По меньшей мере 18 стран Европы сообщили о случаях заражения за последнее десятилетие, при этом наибольшее число инфекций зарегистрировано в Испании, Греции, Италии, Румынии и Германии. Первая вспышка C.auris в ЕС была зафиксирована в больнице Валенсии в 2016 году, где изначально выявили четыре случая среди пациентов отделения интенсивной терапии, а в течение нескольких месяцев их число возросло до 140 в том же учреждении.